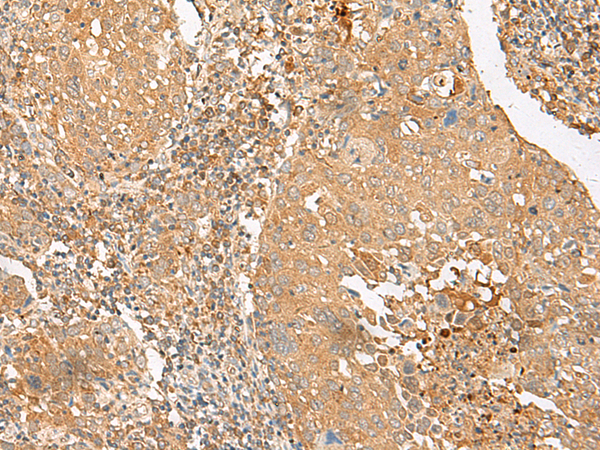

中文名稱: 兔抗SLC2A8多克隆抗體
英文名稱: Anti-SLC2A8 rabbit polyclonal antibody
別 名: solute carrier family 2 member 8; GLUT8; GLUTX1
儲(chǔ) 存: 冷凍(-20℃)
宿 主: Rabbit
相關(guān)類別: 一抗
反應(yīng)種屬: Human, Mouse, Rat
標(biāo) 記 物: Unconjugate
克隆類型: rabbit polyclonal
技術(shù)規(guī)格
|
Background: |
This gene belongs to the solute carrier 2A family, which includes intracellular glucose transporters. Based on sequence comparison, the glucose transporters are grouped into three classes and this gene is a member of class II. The encoded protein, like other members of the family, contains several conserved residues and motifs and 12 transmembrane domains with both amino and carboxyl ends being on the cytosolic side of the membrane. Alternatively spliced transcript variants have been described for this gene. |
|
Applications: |
ELISA, IHC |
|
Name of antibody: |
SLC2A8 |
|
Immunogen: |
Synthetic peptide of human SLC2A8 |
|
Full name: |
solute carrier family 2 member 8 |
|
Synonyms: |
GLUT8; GLUTX1 |
|
SwissProt: |
Q9NY64 |
|
ELISA Recommended dilution: |
5000-10000 |
|
IHC positive control: |
Human cervical cancer and Human colorectal cancer |
|
IHC Recommend dilution: |
30-150 |
購(gòu)物車
幫助
021-54845833/15800441009
